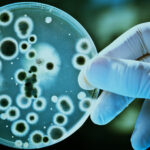

Top Insights
20 Rare Facts About Sanjay Dutt You Didn’t know

We all know Sanjay Dutt aka Sanju Baba very well.
Although the Bollywood is a place that keeps showing up a lot of new faces every day, starts like Sanjay Dutt is among the stalwarts that India reckons.
Sanju Baba has managed to secure his place in the Bollywood and everything related to it and has a different image in the industry and in his fans’ hearts. The life of Superstar Sanjay Dutt has been full of ups-and-downs. After the release of his Biopic “Sanju”, the fans and Bollywood lovers are too keen to know about the hidden facts about Sanjay Dutt.
20 Rare Facts About Sanjay Dutt:
Though all the facts have not been given a place in his biopic “Sanju”, each and every one of them still has a deep impact on his life. So, whether you have watched the Sanju Movie till now or not, here are the 20 rare facts about Sanjay Dutt that you must know as a Baba’s die-hard fan.
1. His parents arranged a poll to decide his name.
Yes! You heard it right. Before his birth, Sanjay’s parents went for a poll for their kid’s name. Out of several names for her son, Nargis Dutt zeroed on Sanjay. And hence, he got his name.

2. His first Silver screen appearance was as a kid artist in the film Reshma Aur Shera.
Sanjay Dutt first appeared in the silver screen as a child Qawwali artist in his father’s film namely, “Reshma Aur Shera”. This was back in the year 1972.

3. Sanjay was sent to a boarding school after being caught smoking by his dad, Sunil Dutt.
When Sanjay Dutt was 11 yrs old, Sunil Dutt his father had caught him smoking the remains of the cigarettes left by Sunil’s friends at his home. After this, he decided to send him to a boarding school.

4. His mother was too excited about Sanjay’s Bollywood Debut as a hero in the movie Rocky. But unfortunately, she died five days prior to the scheduled release.
Sanjay and his mom, Nargis Dutt were too close and attached to each other. She was too excited about his debut as hero, in the movie “Rocky”. Unfortunately, she died just five days prior to the scheduled release of his movie.

5. For the premiere of his film “Rocky”, one seat was intentionally kept vacant in the memory of Nargis Dutt.
Well, this has already been shown in his biopic “Sanju and is sure to have evoked a thousand emotions. It is true that at the premiere show of his film “Rocky”, one seat was left empty in the loving memory of Sanjay Dutt’s mother, Nargis since she had wanted to attend the premiere show too.

6. Sanjay spent 2 years at a rehabilitation centre in Texas, USA to get rid of Drug addiction.
After knowing about his son’s drug addiction, Sunil Dutt sent him to a rehab centre in Texas where Sanjay spent almost two years to get rid of addiction completely.

7. Sanjay Dutt and actress Tina Munim had been in a romantic relationship for about 2 years.
It is true that Sanjay Dutt and Tina Munim were in a serious relationship but she had eventually called it quits owing to his over-possessive nature and drug addiction. Their relationship lasted for two years.

8. Sanjay Dutt married Richa Sharma in 1987 who died due to a brain tumour in 1996.
Sanjay Dutt first married Richa Sharma and was living their lives happily with each after. But the actress died of a brain tumour in the year 1996. Sanjay and Richa had a daughter named as Trishala who currently lives with her grandparents in the USA.
After her death, Sanjay married to a model named as Rhea Pillai (1998). They separated in the year 2005.

9. Madhuri Dixit and Sanjay Dutt were said to have been in a romantic relationship
Another love affair that has gained enough rumours is between Sanjay Dutt and Madhuri Dixit. Although it is said that was only a rumour, both the actors were seen together many times. Madhuri Dixit officially broke up with the actor after the allegation of Arms possession in the year 1993.

10. Sanjay’s sisters Namrata and Priya Dutt didn’t attend the wedding of Sanjay and Manyata
After getting divorced with Rhea Pillai, Sanjay married Manyata. But, due to some internal family issues, Sanjay’s sisters Namrata and Priya Dutt didn’t attend the function.

11. Subhash Ghai had once slapped Sanju for unruly behaviour with Padmini Kolhapure on sets of “Vidhaata”
Another incident that gained enough heat is when Director Subhash Ghai slapped Sanjay Dutt in front of the public for misbehaving the actressPadminiKolhapure on the sets of “Vidhaata”. After this incident, Subhash Ghai signed Jackie Shroff in place of Sanjay Dutt for his next Film, “Hero”.

12. Although his father and sisters were associated with Congress party, he joined Samajwadi party instead of Congress.
Being from a family that is influenced with Indian National Congress, Sanjay Dutt opted to stand with the Samajwadi party. This was despite the truth that Sunil Dutt his father, and sisters were associated with the Congress.

13. On the sets of movie “Yalgaar”, Feroz Khan introduced Sanjay to Dawood Ibrahim.
We all are aware of the underworld connection of Sanjay Dutt that somehow ruined his life and affected his career too. But, the individual who introduced Sanjay with the Don Dawood Ibrahim was the Director/Actor/Producer Feroz Khan on the sets of movie “Yalgaar”.

14. Sanjay was arrested 3 weeks prior to the scheduled release of the hit movie “Khalnayak” due to involvement in Mumbai blasts.
Khalnayakis considered as a milestone of Sanjay’s career as a Bollywood established actor. However, he got arrested three weeks when the movie was all set to screen in the theatres.

15. Sunil Dutt informed police about Sanjay’s arrival from Mauritius. He was then arrested under TADA Act.
Sunil Dutt himself informed the police about the arrival of Sanjay’s flight from Mauritius. The actor was arrested right through when he landed at the Mumbai Airport.

16. Sanjay was allowed to have electronic cigarettes by the authorities after citing migraine attacks and withdrawal symptoms in jail
Being a drug addict, Sanjay faced a tough time in jail. He got migraine attacks, and other serious health issues due to which the jail authorities allowed him to use the electronic cigarettes to cope up with the health issues.

17. Being extremely fitness conscious, Sanjay Dutt continued to exercise using the mud pots and trashcans.
We all know about the fitness enthusiasm of Sanjay Dutt. He has the best physique of all the actors of his age. However, when he was in jail, he couldn’t get enough equipment for his regular exercise session. So, he made his personalized gym accessories by using the mud pots and trashcans.

18. After his release from jail, Sanjay used to sleep on his room floor at his home for fifteen days, or so.
Addicted to jail’s hard bed, Sanjay Dutt couldn’t sleep on his luxurious bed at home. To cope up with the situation, he used to sleep on the floor for fifteen days to get back to the normal usual routine.
19. The days spent in jail made Sanjay a man who is concerned for his family and wants to spend quality time with them.
The numerous days Sanjay spent in jail, helped him to know the value of family and friends. Now, he spends most of his time with family and reading good quality books along with working on the Bollywood projects.

20. Sanjay has a great feeling for his parents and has tattooed their name
Sanjay Dutt has a special place in his heart for his parent, and also he is love with the tattoos. Combining these two, he has tattooed his father’s name on his torso, and his mother’s name in the arm.

So, these were some of the unknown (at least less-known certainly) facts about Sanju. By looking at these facts, and after watching the Sanjay Dutt Biography, we can only say that this man has undergone many things that may crush a man as a human. However, he still has faith in humanity and the legal system of India, which is nothing less than a miracle. In other words, Sanjay Dutt is a real legend who has suffered a lot but still believes in the good things in life.
Recent Posts
Categories
- Accessories5
- Apps23
- Bollywood282
- Business33
- Cars8
- Celebrities62
- Cricket20
- Digital Marketing29
- Education549
- EML India52
- EML UK6
- Entertainment394
- Events46
- Featured4
- Finance11
- Fitness4
- Guest Posts187
- Health30
- Inspiration4
- Jobs Recruitment31
- Lifestyle38
- Merry Christmas9
- Mobile Phones25
- News35
- Prepapration Tips23
- Relationship4
- Results87
- Social Media13
- Sports26
- Startups5
- Tech1
- Technology146
- Travel23
- Uncategorized2
- Web Design1
Related Articles
Shahrukh Khan’s Zero Movie Review and Star Rating | Film Budget | IMDB Reviews
Shahrukh Khan’s Zero movie review and star rating, Zero IMDB Reviews- With...
ByedumovliveDecember 23, 2018Shahrukh Khan’s Zero Box Office Collection: Friday and Saturday Earnings
Shahrukh Khan’s Zero first day box office collection and Zero 2nd day...
ByedumovliveDecember 23, 2018Ranveer Singh and Deepika Padukone Wedding/ Mehndi Pics: Both Are Looking Adorable
RANVEER Singh and Deepika Padukone become the hottest looking couple in their...
ByedumovliveNovember 23, 2018

Leave a comment